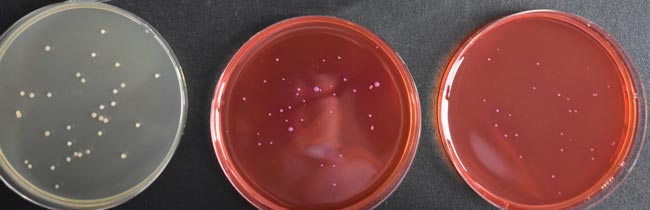
产品细节图片2

相关产品推荐更多 >
万千商家帮你免费找货
0 人在求购买到急需产品
- 详细信息
- 文献和实验
- 技术资料
- 库存:
999
- 英文名:
Burkholderia Cepacia Selective Agar
- 保质期:
三年
- 供应商:
青岛海博生物
- 规格:
250g
用途:用于药品中洋葱伯克霍尔德菌的选择性分离培养。
添加剂:
每瓶需配5盒HB9218a BCSA抑菌剂(1ml*5);
每200ml培养基添加1支HB9218a BCSA抑菌剂(1ml*5)。
成分(g/L)
| Casein Peptone/胰蛋白胨 | 10.0 |
| Sucrose/蔗糖 | 10.0 |
| Yeast Extract/酵母提取物 | 1.5 |
| Crystal Violet/结晶紫 | 0.002 |
| Lactose/乳糖 | 10.0 |
| Sodium Chloride/氯化钠 | 5.0 |
| Phenol Red/酚红 | 0.08 |
| Agar/琼脂 | 14.0 |
| pH值6.8±0.3 | 25℃ |
用法:
称取本品50.6g,加热煮沸完全溶解于1000ml纯化水中,分装三角瓶,121℃高压灭菌15分钟,冷却至45℃~50℃时,每200ml培养基中加入1支BCSA抑菌剂(含庆大霉素2mg,万古霉素0.5mg,多粘菌素B120000U),混合均匀,倾入无菌平皿,备用。
洋葱伯克霍尔德菌选择性琼脂(BCSA)(USP标准)微生物质控结果:

洋葱伯克霍尔德菌 ATCC25416
洋葱伯克霍尔德菌 ATCC BAA-245

多噬伯克霍尔德氏菌 ATCC BAA-247
洋葱伯克霍尔德菌选择性琼脂(BCSA)(USP标准)微生物灵敏度试验:
按标签用法制备培养基,接种以下质控菌株,放置30-35℃需氧培养48-72小时。


风险提示:丁香通仅作为第三方平台,为商家信息发布提供平台空间。用户咨询产品时请注意保护个人信息及财产安全,合理判断,谨慎选购商品,商家和用户对交易行为负责。对于医疗器械类产品,请先查证核实企业经营资质和医疗器械产品注册证情况。
文献和实验1 主题内容与适用范围本文规定了食品中沙门氏菌的检验方法。本文适用于航空食品的检验。2 设备和材料吸管(1ml、10ml)、恒温培养箱(36±1℃、42℃)、冰箱、均质器、振荡器、平皿、稀释瓶、天平、显微镜、接种棒等3 培养基和试剂缓冲蛋白胨水(BP)、氯化镁孔雀绿增菌液、四硫酸钠煌绿(TTB)增菌液、亚硒酸盐胱氨酸(SC)增菌液、亚硫酸铋琼脂(BS)、DHL琼脂、HE琼脂、WS琼脂、SS琼脂、三糖铁琼脂、蛋白胨水、靛基质试剂、尿素琼脂(pH7.2)、氰化钾(KCN)培养基、氨基酸脱羧酶试验
Burkholderia cepacia 洋葱伯克霍尔德菌 Burkholderia diminuta 洋葱伯克霍尔德菌 Burkholderia gladioli 唐菖蒲伯克霍尔德菌 Burkholderia pseudomallei 类鼻疽伯克霍尔德菌 Buttiauxella agrestis 乡间布丘菌 Campylobacter coli 大肠弯曲杆菌
Brevendimonas vesicularis 泡囊短波单胞菌 Brevibacterium casei 乳酪短杆菌 Brevibacterium epidermidis 表皮短杆菌 Brevibacterium spp 短杆菌属某些种 Brucella spp 布鲁菌属某些种 Budvicia aquatica 水生布戴约维采菌 Burkholderia cepacia 洋葱伯克霍尔德菌
技术资料暂无技术资料 索取技术资料










